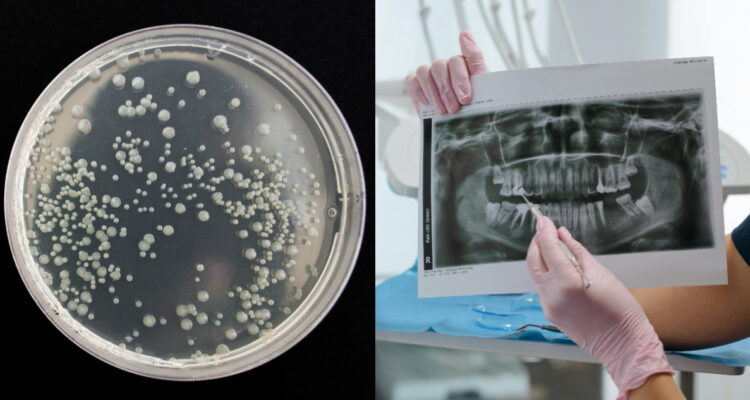
Descubren que una bacteria común de la boca humana puede “derretir” algunos tipos de cáncer

Científicos de la fundación Guy’s and St Thomas’ y del King’s College de Londres, en Reino Unido, descubrieron que una bacteria común de la boca humana puede “derretir” algunos tipos de cáncer, como el de cabeza y cuello.
De acuerdo con The Guardian, los investigadores realizaron un estudio que determinó que los pacientes con estos tipos de cáncer, que contenían la bacteria ‘fusobacterium’, tuvieron resultados más positivos con respecto a los que no la tenían.
Ahora, investigan los mecanismos detrás del vínculo entre fusobacterium y el cáncer de cabeza y cuello. “La otra cosa que descubrimos es que en cultivos celulares esta bacteria es capaz de matar el cáncer“, comenta el Dr. Miguel Reis Ferreira, autor principal del estudio.
“Lo que estamos descubriendo es que este pequeño bicho está provocando un mejor resultado gracias a algo que está haciendo dentro del cáncer. Por eso, estamos buscando ese mecanismo en este momento y debería ser el tema de un nuevo artículo en un futuro muy cercano”, agrega.
¿Una bacteria que puede “derretir” el cáncer?
Según Reis, la fusobacterium desempeña un papel más complejo de lo que se conocía en su relación con el cáncer: “básicamente, derrite las células cancerosas de la cabeza y el cuello. Sin embargo, este hallazgo debería equilibrarse con su papel conocido en el empeoramiento de cánceres como los de intestino”.
Los expertos identificaron las bacterias de interés y luego estudiaron en un laboratorio sus efectos en las células cancerígenas. Asimismo, analizaron datos de 155 pacientes con cáncer de cabeza y cuello.
Los resultados fueron sorprendentes, ya que anteriormente otros estudios relacionaban la presencia de la fusobacterium con la progresión de algunos cánceres, como el del intestino.
Sin embargo, tras las pruebas introduciéndola en células de cáncer de cabeza y cuello, encontraron una reducción del 70% al 99%. Además, en pacientes en los que se encontró fusobacterium mientras tenían este cáncer, hubo un 65% menos de riesgo de muerte en comparación a los que no la tenían.
“Si la aplicas en cantidades muy bajas sobre el cáncer, comienza a matarlo muy rápidamente”, aseguró Reis.
Los científicos creen que este hallazgo es un buen pronóstico para el cáncer de cabeza y cuello, que incluye boca, garganta, laringe, nariz y senos paranasales, ya que no se han visto muchos avances en terapias en los últimos 20 años.
“Nuestros hallazgos son notables y muy sorprendentes. Tuvimos un momento de inspiración cuando descubrimos que nuestros colegas internacionales también habían encontrado datos que validaban el descubrimiento“, completó Anjali Chander, de la clínica sénior del King’s College y también autora principal de la investigación.







 Enviando corrección, espere un momento...
Enviando corrección, espere un momento...